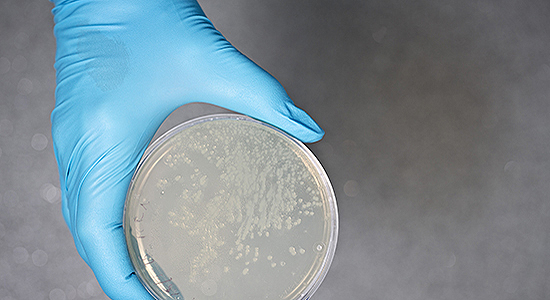
Foto af Petriskål

Det forsker vi i
Dansk Veterinær Konsortium
Dansk Veterinær Konsortium (DK-VET) repræsenterer et samarbejde mellem Københavns Universitet (KU) og Statens Serum Institut (SSI), hvor vi sammen forvalter den veterinære myndighedsaftale. Aftalen, der er indgået mellem Fødevareministeriet og Københavns Universitet, omfatter en bred vifte af opgaver, der sikrer dyrevelfærd og beskytter folkesundheden. Vi håndterer udfordringer inden for dyresundhed, herunder overvågning af sygdomme og rådgivning til myndighederne.